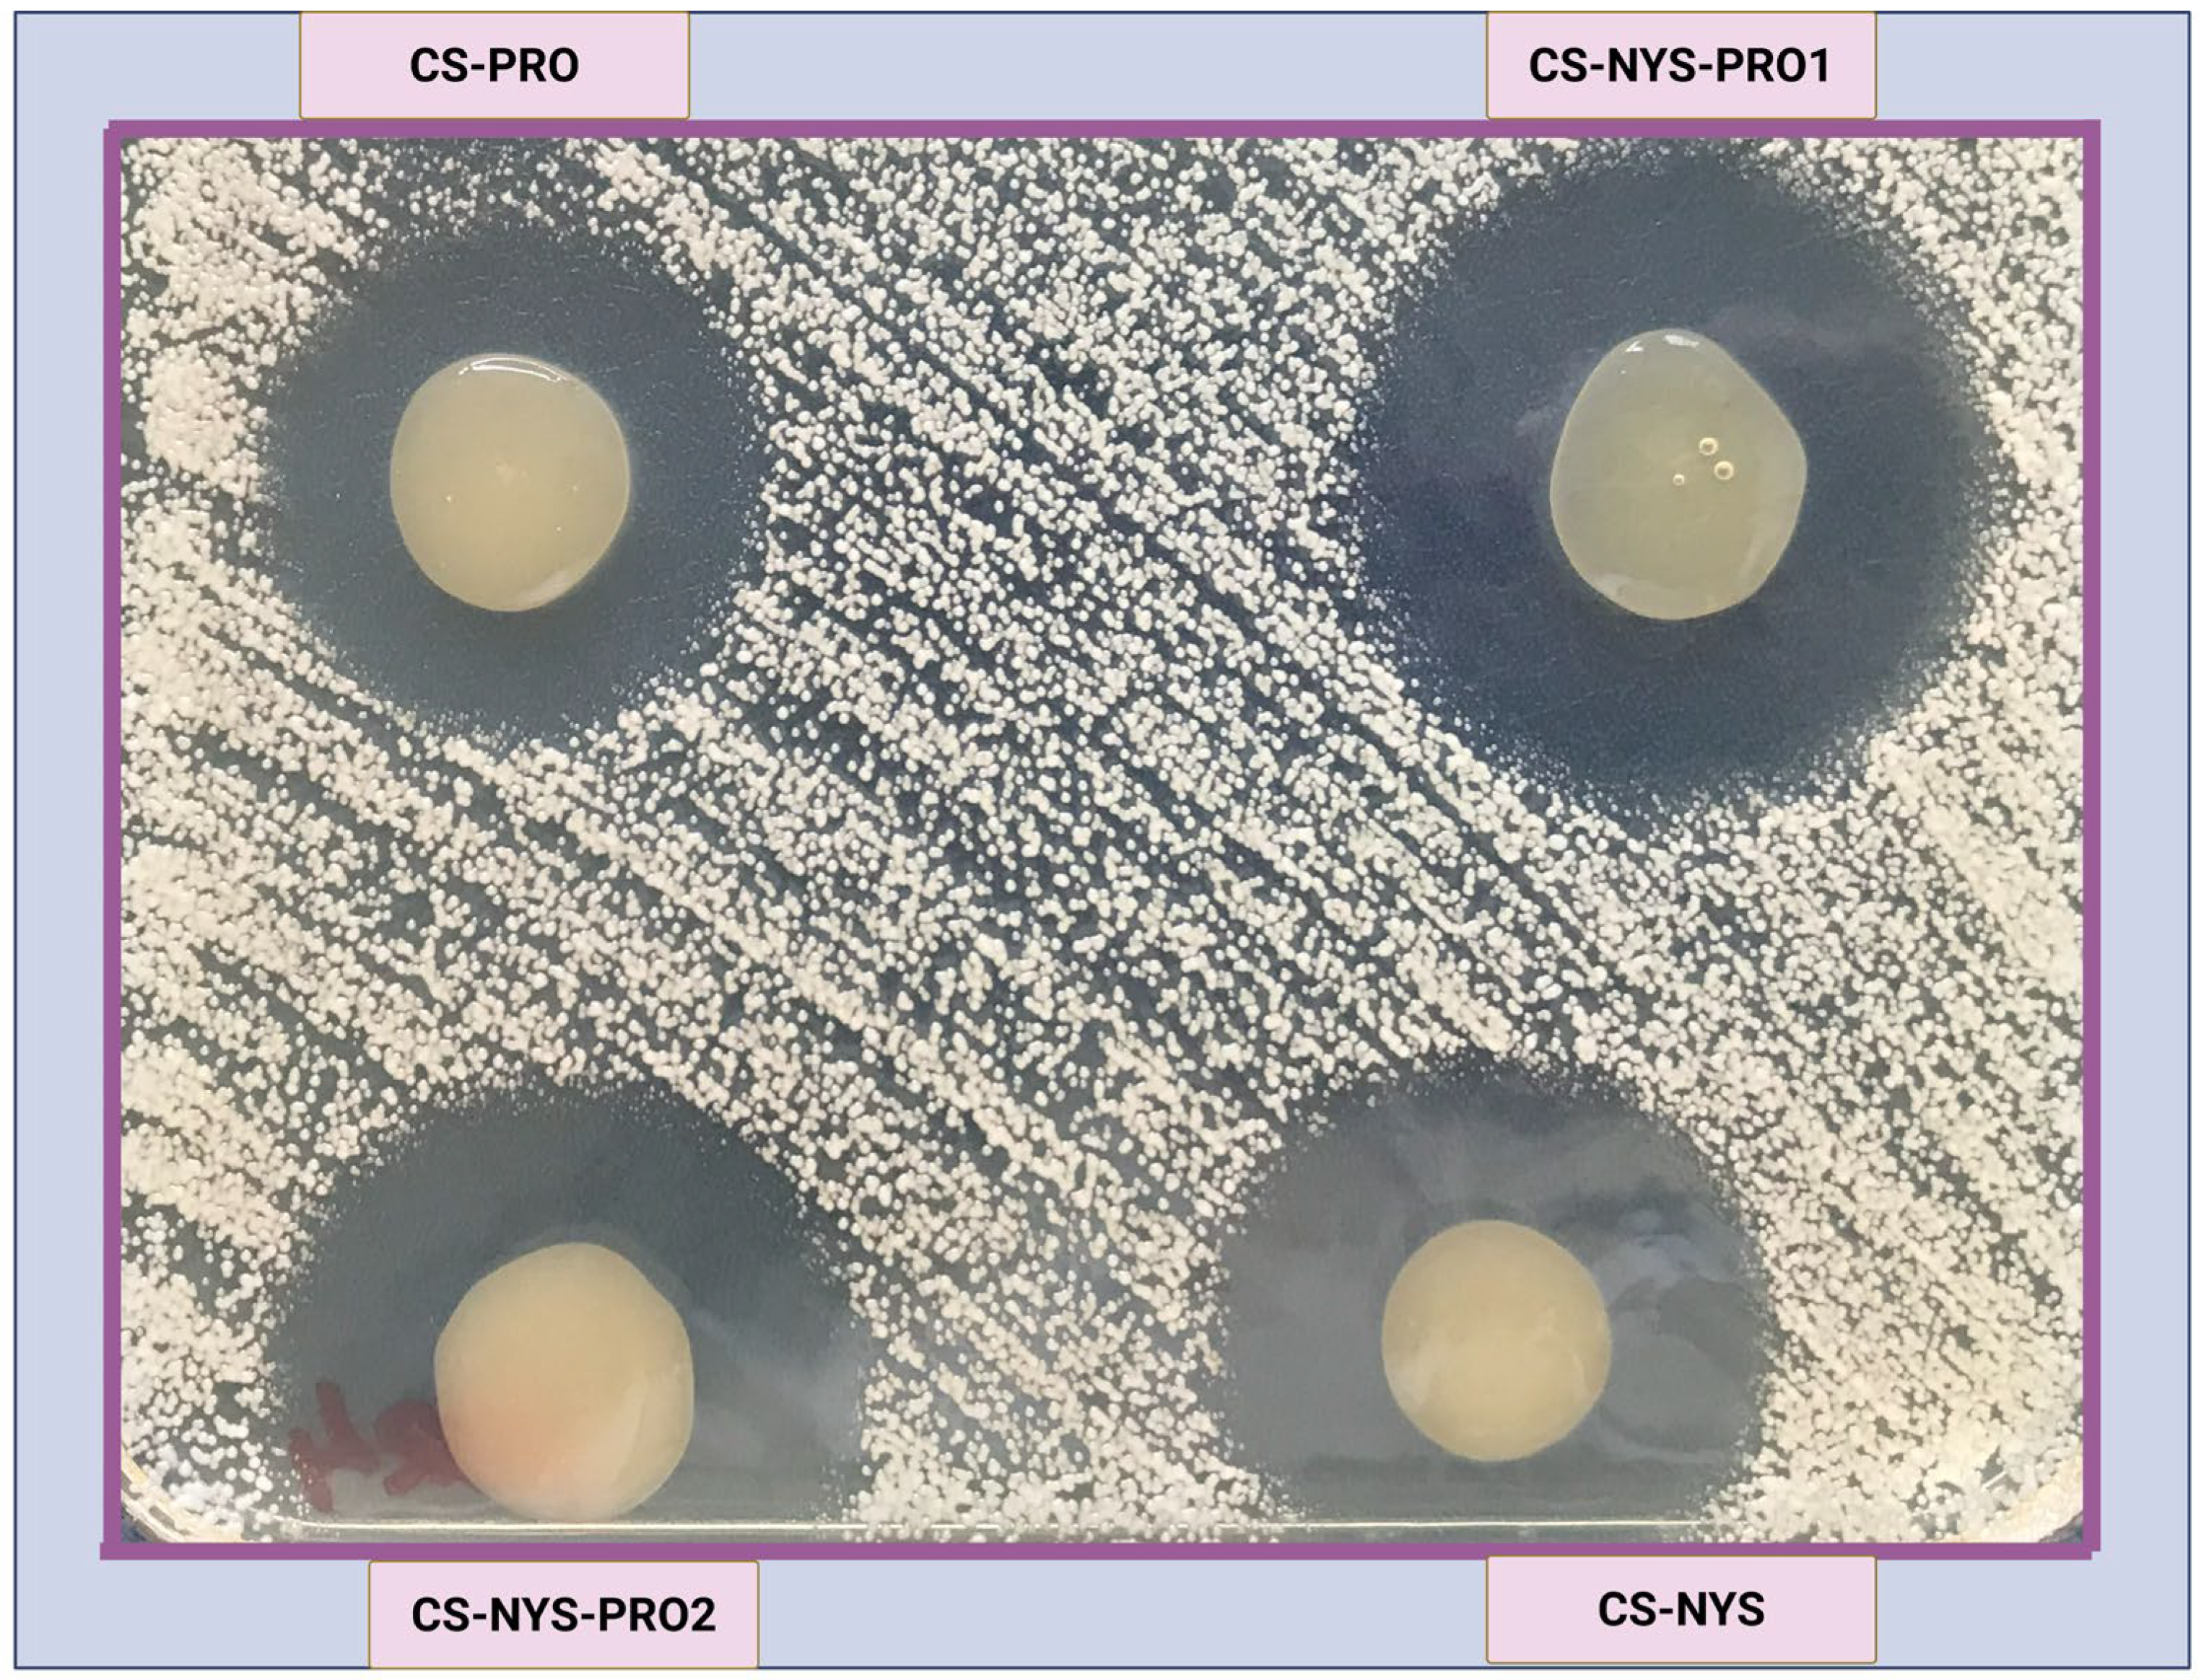
Gels 11 00498 g004

1. Introduction
Candida auris is an emerging multidrug-resistant fungal pathogen that has become a global concern due to its capacity to persistently colonize the skin and cause life-threatening infections, particularly in immunocompromised individuals [
1]. This global concern stems not only from the pathogen’s resistance to multiple antifungal drugs but also from its ability to persist in healthcare settings and its high transmission potential [
2]. First identified in 2009 from the ear canal of a patient in Japan,
C. auris is taxonomically related to
Candida haemulonii but exhibits distinct clinical and epidemiological features [
3]. Since its discovery,
C. auris has rapidly disseminated across six continents, with outbreaks reported in over 45 countries and high mortality rates from bloodstream infections reaching up to 60% [
4].
Skin colonization is considered a major reservoir for this fungal pathogen. Also,
C. auris is notoriously difficult to eliminate from the skin and mucosal surfaces of colonized individuals, primarily due to its ability to form resilient biofilms. These biofilms persist on abiotic surfaces and are resistant to commonly used antifungals like azoles, echinocandins, and polyenes [
5,
6,
7]. This yeast has been described as a “stealth” or “incognito” pathogen due to its unusual biological traits that make it difficult to detect, treat, and control [
8,
9]. These include the following: (i)
C. auris exhibits a preference for skin colonization over the gastrointestinal tract or other anaerobic environments, likely due to its poor growth under anaerobic conditions [
10]; (ii) its marked skin tropism enables persistent colonization and rapid patient-to-patient transmission, making it the first fungal pathogen designated as an urgent global public health threat [
1,
8,
10]; (iii) it can survive on abiotic surfaces and medical equipment for prolonged periods, facilitating nosocomial outbreaks even under standard cleaning protocols [
11,
12,
13]; (iv) diagnostic laboratories using conventional phenotypic or biochemical assays frequently misidentify
C. auris, delaying appropriate intervention [
14]; (v) the pathogen exhibits resistance to multiple major classes of antifungal agents, with bloodstream infections associated with mortality rates between 30 and 60% [
4,
15]. For example, in the U.S., for instance, the number of
C. auris skin colonization cases nearly tripled between 2020 and 2021, while invasive infections almost doubled [
16].
Although research on
Candida auris has expanded rapidly since its initial identification, rising from a single publication in 2009 to over 450 in 2024, less than 10% of studies have focused on its skin colonization stage, which is critical for transmission (
Figure 1).
Despite numerous alternative antifungal strategies being explored, including antifungal combinations [
17,
18] drug repurposing, and the development of novel antifungal agents such as small molecules [
19,
20], polymers [
21], and natural product derivatives [
22], as well as innovative approaches like nanoparticles, hydrogels, antimicrobial coatings, and irradiation techniques [
21,
23], no universally effective treatment has been approved. This underscores the urgent need for biocompatible delivery technologies that can overcome fungal resistance and environmental persistence.
Among such systems, chitosan-based hydrogels have attracted considerable interest for combating
Candida species. Derived from chitin, chitosan is biocompatible, biodegradable, mucoadhesive, and intrinsically antimicrobial, making it an ideal for localized, controlled-release formulations [
24]. Its gel-forming ability under mildly acidic conditions allows for the encapsulation and sustained release of hydrophobic antifungals like nystatin [
25]. Furthermore, chitosan hydrogels exhibit favorable physicochemical properties for skin delivery systems, including strong bioadhesiveness and controlled drug release [
26].
Our previous work demonstrated that chitosan-based films and hydrogels loaded with nystatin (NYS) and/or propolis (PRO) exhibit strong antifungal activity against
Candida albicans and
Candida glabrata, while maintaining suitable mechanical properties for mucocutaneous application [
27]. Moreover, Enache et al. investigated the release of insoluble nystatin from physically and chemically modified chitosan hydrogels in simulated fluids, reporting a pronounced antifungal activity against
Candida albicans,
Candida dubliniensis, and
Candida glabrata [
28]. Nystatin was also shown to enhance hydrogel stability through hydrophobic and hydrogen bonding interactions [
28], while propolis a natural resinous compound collected by bees, with antimicrobial and anti-inflammatory properties may exert synergistic effects with NYS, allowing for lower effective doses [
27].
However, as shown in
Figure 1, few researchers have explored the potential use of chitosan in
Candida auris skin decolonization [
29]. This highlights a significant research gap, particularly in light of the urgent need for effective topical formulations capable of disrupting colonization and reduce the risk of nosocomial spread. The scarcity of studies focused on skin-targeted, chitosan-based delivery systems for
C. auris underscores the novelty and relevance of the current investigation.
This study is, to our knowledge, the first to evaluate chitosan-based hydrogels containing both nystatin and propolis as a targeted strategy for the topical decolonization of
Candida auris. Building upon our previous work on chitosan-based films and hydrogels incorporating nystatin and/or propolis previously developed for vulvovaginal and oral candidiasis [
27], here we focus exclusively on hydrogel formulations, optimized for cutaneous application and specifically tailored to address a critically underexplored infection model.
Compared to solid films, hydrogels offer superior hydration, enhanced skin adhesion, and a microenvironment favorable to both antifungal activity and tissue healing [
30]. However, current antifungal treatments, such as commercial nystatin-based ointments (e.g., Nidoflor
®, Mycolog-II
®), often contain synthetic excipients (e.g., corticosteroids, parabens, alcohols) that may cause local irritation or allergic reactions, particularly in sensitive patients. Accordingly, this work proposes a novel, well-tolerated strategy for managing
C. auris colonization by harnessing chitosan’s functional properties and the antifungal synergy of nystatin and propolis in a biocompatible hydrogel matrix. In addition, to gain deeper mechanistic insights into the antifungal action of this formulation, molecular docking analyses were conducted to investigate nystatin interactions with key
Candida auris enzymes, including sterol 14-alpha demethylase (CYP51), a well-known target involved in ergosterol biosynthesis. Notably, this study is the first to explore the potential binding of nystatin to dihydrofolate reductase (DHFR), an essential enzyme in folate metabolism and nucleic acid synthesis, suggesting a possible alternative antifungal mechanism.
2. Results and Discussion
2.1. Hydrogel Preparation and Microstructural Analysis
The preparation and characterization of chitosan-based hydrogels incorporating nystatin and propolis were initially established in our previous work [
27], focusing on antifungal activity against
Candida albicans and
Candida glabrata. These formulations were extensively characterized in the form of films (morpho-structural and mechanical properties) as well as in gel form (rheological properties, dynamic vapor sorption) for their antifungal activity, relevant to muco-cutaneous candidiasis, with perspectives to demonstrate the additive or synergistic effect of these two active principles against other
Candida species. Notably, rheological analysis confirmed that gels containing higher amounts of propolis exhibited predominantly viscous behavior, while those with chitosan and/or nystatin alone showed solid-like characteristics [
27].
Building on this foundation, the current study adapts the hydrogel preparation method, to further explore chitosan-based hydrogels incorporating nystatin and propolis, or topical applications targeting
Candida auris skin decolonization. Thus, chitosan-based hydrogels containing nystatin (CS-NYS), propolis (CS/PRO), or both active agents in different ratios (CS/NYS/PRO1, respectively, CS/NYS/PRO2) were prepared, with slight adaptations tailored to topical applications. A schematic representation of the hydrogel preparation process used here is presented in
Figure 2. This approach ensures reproducibility while allowing us to investigate additional structural and functional properties relevant for skin application and antifungal efficacy against this emerging pathogen.
The microstructural analysis of CS/Nys, CS/Pro, and CS/Nys/Pro hydrogels was performed using polarized light microscopy (PLM), in comparison with pure nystatin powder, as illustrated in
Figure 3. This technique enables the visualization of anisotropic structures and crystalline domains through their birefringence patterns.
Nystatin, a polyene antifungal with low water solubility [
31,
32], typically exists in crystalline form. Therefore, under PLM, nystatin crystals exhibit characteristic birefringence due to their ordered internal lattice, appearing as bright white structures (
Figure 3). This behavior has been previously reported in studies of solid-state nystatin formulations, confirming its crystalline nature [
27,
33].
Upon incorporation into the chitosan hydrogel matrix (CS/NYS), these particles exhibit birefringent coloration, suggesting interactions with the polymeric network and partial microscale dispersion. This observation aligns with previous findings regarding nystatin’s low solubility and crystalline morphology [
27,
28].
In contrast, CS/PRO displays a homogeneous, amorphous texture with no visible birefringent particles, consistent with the known amorphous nature of propolis extracts. The CS/NYS/PRO hydrogel presents a hybrid microstructure, in which birefringent crystalline particles coexist with amorphous regions. This reflects the combined influence of nystatin and propolis on the internal microstructural organization of the gel matrix.
Moreover, PLM analysis indicates a generally uniform distribution of nystatin within the hydrogel formulations, supporting its successful incorporation into the polymeric matrix despite its intrinsic crystallinity. These microstructural variations may influence the antifungal activity of the formulations, which is further evaluated through biological assays against Candida auris. In addition, molecular docking studies can provide insights into the potential interaction mechanisms between nystatin and fungal targets.
2.2. Evaluation of the Antifungal Activity of Hydrogel Formulations Against Candida auris
The in vitro antifungal activity of the chitosan-based hydrogel formulations was evaluated against a panel of ten Candida auris strains (CBS 10913, CBS 18248–18256), using the agar disk diffusion method. After 48 h of incubation at 37 °C, antifungal efficacy was determined by measuring the diameter of the clear zones of inhibition surrounding each hydrogel.
As illustrated in
Figure 4, all hydrogels exhibited antifungal activity in direct contact with
C. auris colonies. However, measurable zones of inhibition extending into the surrounding agar were observed mainly for the nystatin-containing hydrogels (CS-NYS, CS-NYS-PRO1, and CS-NYS-PRO2). Among these, CS-NYS-PRO1 exhibited the largest visible inhibition zone, followed by CS-NYS-PRO2 and CS-NYS, while the CS-PRO formulation (containing only propolis) showed more limited antifungal activity.
The diameters of the inhibition zones across the tested strains (CBS 10913, CBS 18248, CBS 18249, CBS 18250, CBS 18251, CBS 18252, CBS 18253, CBS 18254, CBS 18255, CBS 18256) are presented in
Table 1, along with the corresponding means and standard deviations. CS-NYS-PRO1 showed inhibition zones ranging from 35 to 39 mm, with a mean diameter of 37.5 ± 1.18 mm. CS-NYS-PRO2 ranged from 32 to 36 mm (mean = 34.5 ± 1.51 mm), while CS-NYS showed moderate activity (26–30 mm; mean = 28.3 ± 1.34 mm). The CS-PRO formulation exhibited the smallest inhibition zones (22–26 mm; mean = 23.9 ± 1.29 mm). Statistical analysis (one-way ANOVA, OriginPro v8.5) confirmed significant differences among the formulations (F = 210.36,
p < 0.0001). High dataset consistency was indicated by an R
2 value of 0.946 and a coefficient of variation of 4.2%.
Specifically, CS-NYS-PRO1 exhibited the largest diameter (39 mm) against strain CBS 18251 and maintained strong activity (≥38 mm) against the majority of strains (CBS 10913, CBS 18248, CBS 18249, CBS 18250, CBS 18255, and CBS 18256). CS-NYS-PRO2 exhibited slightly reduced, but still notable, inhibition values (up to 36 mm across four C. auris strains), while CS-NYS provided only moderate inhibition. The limited efficacy of CS-PRO confirms the critical role of nystatin in the formulation. The presence of nystatin appears to be essential for achieving effective antifungal activity beyond the hydrogel–colony interface, and the enhanced performance of CS-NYS-PRO1 may result from improved diffusion and synergistic effects.
Although some variability in inhibition zone diameters was observed among the
C. auris strains (
Table 1), no clear correlation could be established between strain identity and antifungal susceptibility under the test conditions. This suggests that the differences in inhibition may reflect minor phenotypic variations rather than significant resistance heterogeneity. Therefore, all tested strains exhibited similar sensitivity trends, further supporting the robustness of the hydrogel formulations.
The antifungal activity results of the four hydrogel formulations (CS-NYS, CS-PRO, CS-NYS-PRO1, and CS-NYS-PRO2) against
Candida auris were aggregated for each hydrogel formulation.
Figure S1 provides a visual comparative summary of the inhibition zone diameters for each hydrogel formulation, highlighting the statistically significant differences in antifungal efficacy. The thick horizontal bars represent the mean inhibition diameters.
The graph clearly illustrates the superior performance of CS-NYS-PRO1 (mean diameter: 37.5 mm), followed by CS-NYS-PRO2 (34.5 mm). In contrast, CS-NYS and CS-PRO exhibited lower activity, with mean inhibition zones of 28.3 mm and 23.9 mm, respectively. Thus,
Figure S1 complements the numerical data presented in
Table 1 and reinforces the conclusion that the nystatin–propolis combination significantly enhances antifungal activity.
These findings highlight the enhanced antifungal performance of the CS-NYS-PRO1 hydrogel, likely due to the synergistic interaction between nystatin and propolis, and support its potential use for the topical decolonization of Candida auris.
Compared to other antifungal hydrogels, CS-NYS-PRO formulations demonstrate improved activity. For instance, Pandian et al. (2021) [
29] reported inhibition zones of only 20–25 mm against
C. auris, using octenidine-loaded chitosan dressings. Perchyonok et al. tested various nystatin-containing chitosan hydrogels and observed inhibition zones between 7.8 mm and 10 mm against
Candida albicans, while pure nystatin alone reached approximately 20 mm [
25]. However, the combination of nystatin and propolis showed inhibition zones generally below 25 mm against
C. albicans and
C. glabrata [
27]. These findings further underscore the superior efficacy of CS-NYS-PRO1 against
C. auris, a more resistant species, highlighting the therapeutic potential of combining natural bioactive agents with conventional antifungal drugs in advanced topical formulations.
Although no direct comparison with commercial antifungal products was performed in this study, many of which contain synthetic excipients associated with irritation, the chitosan–propolis–nystatin combination offers a promising, naturally derived alternative. Future studies, including time–kill assays and molecular interaction analyses, are warranted to further evaluate its therapeutic potential.
2.3. Evaluation of Time–Kill Assay Test
The time–depletion kinetics against
Candida auris CBS 10913 were evaluated for all hydrogel formulations tested in the disk diffusion assays (CS-NYS, CS-PRO, CS-NYS-PRO1, and CS-NYS-PRO2), in comparison with a control sample. The time–kill curves are shown in
Figure 5 using a logarithmic scale (log
10 CFU/mL) to accurately reflect the wide range of fungal viability over time. For clarity, the exact numerical values at key time points are provided in
Table S1.
As shown in
Figure 5 and
Table S1, at 6 h, the control sample exhibited a slight increase in fungal load (log
10(2.8 × 10
7) ≈ 7.45 CFU/mL), whereas CS-NYS and CS-PRO hydrogels showed moderate reductions (log
10(3.0 × 10
2) ≈ 2.48 and log
10(9.9 × 10
6) ≈ 6.99 CFU/mL, respectively). Notably, CS-NYS-PRO1 and CS-NYS-PRO2 achieved near-complete fungal eradication, with counts dropping below the detectable limit (log
10(<10) < 1 CFU/mL). This corresponds to a >6-log
10 reduction (over one million-fold decrease) in viable fungal cells for the combined formulations compared to the control. CS-NYS alone reduces counts by approximately 5-log
10, while CS-PRO exhibits a modest ~0.5-log
10 reduction. These results highlight the superior fungicidal efficacy of the combined CS-NYS-PRO hydrogels relative to their individual components and the untreated control.
At 24 h, both CS-NYS-PRO1 and CS-NYS-PRO2 maintained their potent fungicidal effects, keeping fungal counts below the detection limit (<10 CFU/mL). CS-NYS also sustained strong activity, reducing viable cells to undetectable levels by 12 h and maintaining this through 24 h. In contrast, CS-PRO showed only a modest reduction (~1–2 log10 decrease) in fungal load even after 24 h. Meanwhile, the control sample continued to exhibit exponential fungal growth, reaching 6.79 × 107 CFU/mL by the 24 h mark.
Notably, both chitosan hydrogels loaded with nystatin and propolis demonstrated rapid and potent fungicidal activity against
Candida auris, outperforming previously reported time–kill assay results for this pathogen. Standard echinocandins (anidulafungin, caspofungin, micafungin) have been shown to be essentially non-fungicidal against
Candida auris in vitro, failing to achieve ≥3-log
10 (99.9%) CFU reductions in time–kill assay [
34,
35]. Amphotericin B, a more commonly used polyene than nystatin, has been reported to cause only transient CFU reductions, with regrowth observed at 12 h even at twice the MIC [
36], or to show no significant inhibition after 24 h [
37]. Moreover, amphotericin B required higher concentrations and prolonged exposure (~9.13 h) to achieve fungicidal effects [
34].
In contrast, the combination of nystatin with propolis embedded in a chitosan matrix achieved the complete killing of Candida auris within 6 h, demonstrating unusually rapid and sustained fungicidal efficacy, with viable cell counts dropping below detectable levels.
The exceptional kill kinetics are particularly significant given the notorious multidrug resistance of
C. auris. This yeast can survive under harsh conditions and is often resistant to azoles, amphotericin B, and even echinocandins [
10,
15]. Thus, achieving a ≥6-log
10 reduction in viable
C. auris with a topical CS-NYS-PRO1 or CS-NYS-PRO2 hydrogel underscores the effectiveness of the combined formulation.
While both formulations were highly effective in the time–kill assay, the performance of CS-NYS-PRO1 is particularly noteworthy when considered alongside the results of the inhibition zone assays (
Table 1,
Figure S1), where it exhibited the largest inhibition diameter despite containing less propolis than CS-NYS-PRO2. This apparent paradox is consistent with our previous findings in
C. albicans [
27], where a higher propolis content was shown to reduce the in vitro release efficiency of nystatin, as crosslinking between polyphenols and chitosan hinders the diffusion of NYS through the resulting polymeric network. Moreover, the structural and functional advantages of a lower propolis content, also supported by rheological behavior, led to a reduction in fungal loads from approximately 1.24 × 10
7 CFU/mL to undetectable levels (<10 CFU/mL) for
C. albicans [
27].
Based on these findings, CS-NYS-PRO1 appears to offer a more balanced and effective formulation with clear translational relevance, supporting its potential development as a decolonization or infection-prevention agent in clinical settings. Consequently, the morphological changes induced in C. auris by this formulation were further investigated using scanning electron microscopy (SEM).
2.4. Evaluation of Morphological Changes in C. auris byScanning Electron Microscopy (SEM)
To further investigate the morphological impact of hydrogel treatment on
Candida auris, high-resolution scanning electron microscopy (SEM) analysis was performed on CBS 10913 strain cells before and after exposure to the CS-NYS-PRO1 hydrogel.
Figure 6a shows untreated
C. auris cells from the control sample, which display the typical oval yeast morphology with well-defined, smooth surfaces and clear cell boundaries, indicative of healthy, intact membranes, as also reported by others [
38]. In contrast,
Figure 6b presents
C. auris cells treated with the CS-NYS-PRO1 hydrogel, revealing pronounced structural alterations. These include irregular and collapsed cell morphologies, surface roughening, and inhibited cell separation. Most notably, the leakage of cytoplasmic content was observed in multiple cells, suggesting severe membrane disruption.
These morphological aberrations indicate that the hydrogel compromises membrane integrity and cellular architecture, likely due to the combined antifungal mechanisms of nystatin targeting ergosterol and propolis, which may enhance oxidative stress and increase membrane permeability.
To strengthen the SEM-based observations, we performed a quantitative analysis using Fiji/ImageJ coupled with Trainable Weka Segmentation, as detailed in
Figure S2 in the Supplementary Material. The image analysis approach, including segmentation and quantitative particle analysis, was adapted from the method described by Vyas et al. (2016), which demonstrated biofilm removal efficiency quantification using SEM and image analysis [
39].
In untreated
Candida auris samples, cellular structures occupied 83.91% of the image area (total area = 256,562 pixels
2; average object size = 64,140.5 pixels
2), with regular, well-defined morphology. Conversely, samples treated with the CS-NYS-PRO1 hydrogel exhibited a drastically reduced cell-occupied area of only 3.64% (total area = 9784 pixels
2; average object size = 3.6 pixels
2), indicative of extensive cellular fragmentation and disruption. Perimeter measurements also decreased significantly, further confirming the loss of cellular integrity. Quantitative analysis thus supports the antifungal efficacy of the CS-NYS-PRO1 hydrogel by revealing over a 95% reduction in cell area (calculated using Equation (S1) in the
Supplementary Materials), reflecting significant structural damage and impaired cell morphology following treatment.
In addition, these quantitative SEM outcomes are consistent with the significant reduction in fungal viability observed in both agar diffusion and time–kill assays, reinforcing the hypothesis that the CS-NYS-PRO1 hydrogel induces rapid membrane damage and cellular disintegration in C. auris. Thus, SEM findings provide direct ultrastructural evidence supporting the antifungal efficacy of this chitosan-based hydrogel formulation and its potential application in topical decolonization strategies against multidrug-resistant fungal pathogens.
These findings are in line with previously reported effects of polyene antifungals, such as nystatin, which bind in the fungal membrane, forming size-selective pores through hydrophobic interactions between the lipophilic segment of nystatin and the sterol, leading to the loss of cytoplasmic integrity [
40]. To further support the mechanistic understanding at the molecular level, docking studies were performed.
2.5. Molecular Docking Simulations of Nystatin Binding Mechanisms
As reported by Sousa et al. [
40], in addition to their well-established membrane-disruptive activity, polyene antifungals such as nystatin may also act by inducing oxidative stress, DNA damage, and protein and lipid oxidation. These findings suggest that intracellular targets might contribute to their antifungal mechanism. Therefore, to gain deeper mechanistic insights, molecular docking analyses were conducted for nystatin with both sterol 14-alpha demethylase (CYP51), a key enzyme involved in ergosterol biosynthesis [
41], and dihydrofolate reductase (DHFR) from
Candida auris, an essential enzyme in folate metabolism and nucleic acid synthesis [
42].
2.5.1. In Silico Analysis of Nystatin Interaction with Ergosterol Biosynthesis Enzyme (CYP51)
As polyene antifungals, azoles, and allylamines exert their antifungal activity by interfering with ergosterol biosynthesis at different stages [
40], the crystal structure sterol 14-alpha demethylase (CYP51) from
Candida albicans (PDB ID: 5FSA) was retrieved from the Protein Data Bank and used to assess the potential binding interactions of nystatin with this membrane-associated enzyme. As detailed in
Table 2, the structural characterization of sterol 14-alpha demethylase catalytic domain (CYP51, PDB ID: 5FSA) using YASARA Structure software revealed a protein composed of 484 amino acid residues, with a molecular weight of 55.6 kDa and a radius of gyration (Rg) of 22.82 Å. The solvent-accessible surface area was calculated to be 20,512 Å
2. The amino acid composition showed a predominance of leucine (8.5%), lysine (7.2%), and threonine/serine (6.6% each), with a nearly balanced net charge (−1), resulting from a close ratio of positively (Lys, Arg) and negatively (Glu, Asp) charged residues. Secondary structure analysis indicated a dominant α-helical content (47.5%), followed by random coils (30.8%), β-sheets (12.6%), turns (8.1%), and a minor presence of 3
10-helices (1.0%).
Molecular docking simulations were carried out using AutoDock Vina within the YASARA Structure software. A total of 100 docking runs were performed for nystatin (ligand) against the catalytic domain of sterol 14-alpha demethylase receptor (PDB ID: 5FSA). The results yielded 19 distinct binding poses, clustered based on a 5.0 Å RMSD threshold.
The best docking conformation, representing the most favorable interaction mode, is illustrated in
Figure 7. It involved extensive interactions with 25 amino acid residues, including ASN187, MET189, LYS190, GLU194, PHE213, ARG215, SER216, ALA218, GLN219, SER222, ASP225, LYS226, GLY227, PHE228, THR229, PRO230, ILE231, HIS310, ASP504, SER507, MET508, LEU511, PRO512, THR513, and GLU514. Nystatin exhibited a calculated binding energy (Eb) of −9.436 kcal/mol and an estimated dissociation constant (Kd) of 0.121 µM, indicating a strong and stable interaction with the receptor, supporting the high affinity of nystatin for the receptor.
According to the docking analysis (
Figure 7), nystatin interacts with 25 amino acid residues on the receptor primarily through hydrophobic contacts. This supports the hypothesis reported in the literature that nystatin forms size-selective pores via hydrophobic interactions between its lipophilic segments and sterol molecules, ultimately causing loss of cytoplasmic integrity [
40].
Additionally,
Table S2 in the Supplementary Materials, which summarizes the interaction descriptors obtained from the in silico molecular docking between nystatin (ligand) and the CYP51 receptor (PDB ID: 5FSA), shows that alongside 22 hydrophobic contacts, nystatin also forms 3 hydrogen bonds (inset in
Figure 7), reflecting a strong and stable binding. Hydrogen bond analysis reveals three key hydrogen bonds that stabilize the complex: between nystatin’s nitrogen and the oxygen atom of LYS226 (2.22 Å, 3.27 kcal/mol), and between nystatin’s oxygen and the oxygen atoms of ASP504 (2.31 Å, 1.87 kcal/mol) and SER507 (2.41 Å, 1.94 kcal/mol). The total hydrogen bond energy sums to 7.09 kcal/mol, indicating a significant contribution of these bonds to the overall ligand–receptor interaction. Notably, all three hydrogen bonds are accepted by receptor atoms, with none donated by the ligand.
These extensive hydrophobic and hydrogen bonding interactions observed in the best docking conformation strongly support the high binding affinity and specificity of nystatin for the CYP51 active site. Given that CYP51 plays a critical role in ergosterol biosynthesis, essential for fungal cell membrane integrity [
41], these findings provide a molecular basis for the antifungal efficacy of nystatin observed in our experimental assays. Moreover, the stable binding mode suggests that nystatin effectively inhibits CYP51 function, disrupting ergosterol production and contributing to membrane destabilization and fungal cell death.
2.5.2. In Silico Insights into the Interaction of Nystatin with Candida auris Dihydrofolate Reductase
Although nystatin is traditionally recognized for its membrane-targeting antifungal mechanism, we explored the possibility of alternative or complementary mechanisms involving intracellular targets. Dihydrofolate reductase (DHFR) from
Candida auris (PDB ID: 7ZZX), an enzyme critical for folate metabolism and nucleic acid synthesis, represents a validated antifungal target [
42]. Therefore, DHFR was selected as a model receptor to investigate potential binding interactions with nystatin.
The structural and compositional features of crystal structure of
Candida auris DHFR (PDB ID: 7ZZX) were determined through in silico analysis using the YASARA Structure software (version v.20.8.23) and are summarized in
Table S3, in the Supplementary Materials. The balanced distribution of positively and negatively charged residues (net charge = 0) may contribute to the electrostatic neutrality and structural stability of the receptor. Furthermore, the coexistence of polar and non-polar amino acid residues supports the potential for diverse interactions, including hydrogen bonds and hydrophobic contacts. The high proportion of ordered secondary structures (36.6% β-sheets and 23.3% α-helices) underlines the receptor’s conformational rigidity, advantageous for reliable molecular docking simulations.
Molecular docking simulations generated 100 binding poses using AutoDock Vina. The best-scoring pose, based on binding energy and spatial orientation within the DHFR active site, is shown in
Figure 8. Nystatin exhibited a calculated binding energy (
Eb) of −8.48 kcal/mol and an estimated dissociation constant (
Kd) of 0.611 µM, indicating a relatively strong and stable interaction with the receptor.
In this complex, nystatin forms multiple stabilizing interactions with twenty-one amino acid residues, including two hydrogen bonds: one between its polar head and the side chain of ASP151 (2.15 Å) and another with GLU148 (2.24 Å), as evidenced in the inset of
Figure 8. Additionally, 16 hydrophobic contacts with an average length of 4.23 ± 0.40 Å further stabilize the complex. These results support the hypothesis that nystatin may interact directly with DHFR and potentially inhibit its enzymatic function.
Molecular docking results (binding energy and dissociation constant) suggest that nystatin binds more strongly to sterol 14-alpha demethylase (CYP51) compared to dihydrofolate reductase (DHFR). Although the affinity for DHFR is slightly lower, it still indicates a relatively strong and stable interaction, suggesting that nystatin may exert its antifungal effects through multiple targets. Compared to classical antifolate inhibitors such as pyrimethamine and cycloguanil—known to exert potent DHFR inhibition [
34], nystatin demonstrates a comparable binding affinity. While classical antifolates inhibit DHFR through direct competition at the active site, nystatin is traditionally known for disrupting fungal membranes. Thus, alongside the strong binding affinity observed for CYP51, the notable interaction of nystatin with DHFR suggests that its antifungal activity may involve multiple mechanisms, both at the membrane level and intracellularly. This dual-target potential could enhance the overall efficacy of the CS-NYS-PRO1 hydrogel against multidrug-resistant
Candida auris strains, offering a broader mechanistic basis for its antifungal properties.
This hypothesis introduces an intriguing perspective on nystatin’s antifungal action and warrants further investigation. While the docking results are promising, in vitro and in vivo experiments are essential to validate the biological relevance and therapeutic implications of this potential DHFR-targeting mechanism.
3. Conclusions
Chitosan-based hydrogels with nystatin and/or propolis were structurally characterized, confirming the partial dispersion of nystatin and the amorphous nature of propolis within the formulations. The CS-NYS-PRO hydrogels exhibited a microstructure combining both crystalline and amorphous regions, which may contribute to a synergistic effect at the microstructural level.
The bio-evaluation of the hydrogels confirmed their significant antifungal activity against a diverse panel of fluconazole-resistant C. auris strains. Among all tested variants, CS-NYS-PRO1 demonstrated the most pronounced fungicidal effect, as reflected by the largest inhibition zones in disk diffusion assays and the rapid reduction in viable fungal cells in time–kill studies. Within 6 h of exposure, viable counts dropped to below detectable levels (<101 CFU/mL), indicating a rapid and sustained killing effect. These data strongly suggest a synergistic antifungal mechanism between nystatin and propolis when co-delivered in a chitosan matrix.
Scanning electron microscopy of treated C. auris cells revealed extensive morphological damage, including membrane disruption, cytoplasmic leakage, and abnormal cell shapes, which corroborate the rapid fungicidal kinetics observed. Such ultrastructural alterations provide strong evidence for the combined physical and chemical modes of action of the hydrogel components. Together, the in vitro mycological results validate the antifungal performance of the CS-NYS-PRO hydrogels and highlight their potential utility in skin decolonization applications. Importantly, the formulations exhibited strong bioactivity under skin-mimicking conditions, making them promising candidates for use in topical therapies to manage C. auris colonization and prevent transmission in high-risk clinical environments.
Molecular docking studies revealed that nystatin binds strongly to Candida auris sterol 14-alpha demethylase (CYP51), a key enzyme in ergosterol biosynthesis, and also interacts notably with dihydrofolate reductase (DHFR), an essential enzyme involved in folate metabolism and DNA synthesis. Although the binding affinity for DHFR is slightly lower than for CYP51, it remains relatively strong, suggesting a possible complementary intracellular mechanism of antifungal action alongside the well-established membrane-disruptive effects of nystatin. This dual-target potential represents a novel insight into the multifaceted antifungal activity of nystatin, potentially enhancing its efficacy against multidrug-resistant C. auris strains.
Future work should aim to evaluate the hydrogels’ performance in more complex in vivo or ex vivo skin models and assess their safety, retention, and efficacy profiles under real-use conditions. Additionally, formulation optimization, including drug-loading capacity and rheological behavior, may further improve clinical applicability. Overall, these findings support the continued investigation of chitosan-based hydrogel platforms as a non-invasive strategy to combat resistant fungal pathogens on skin surfaces.